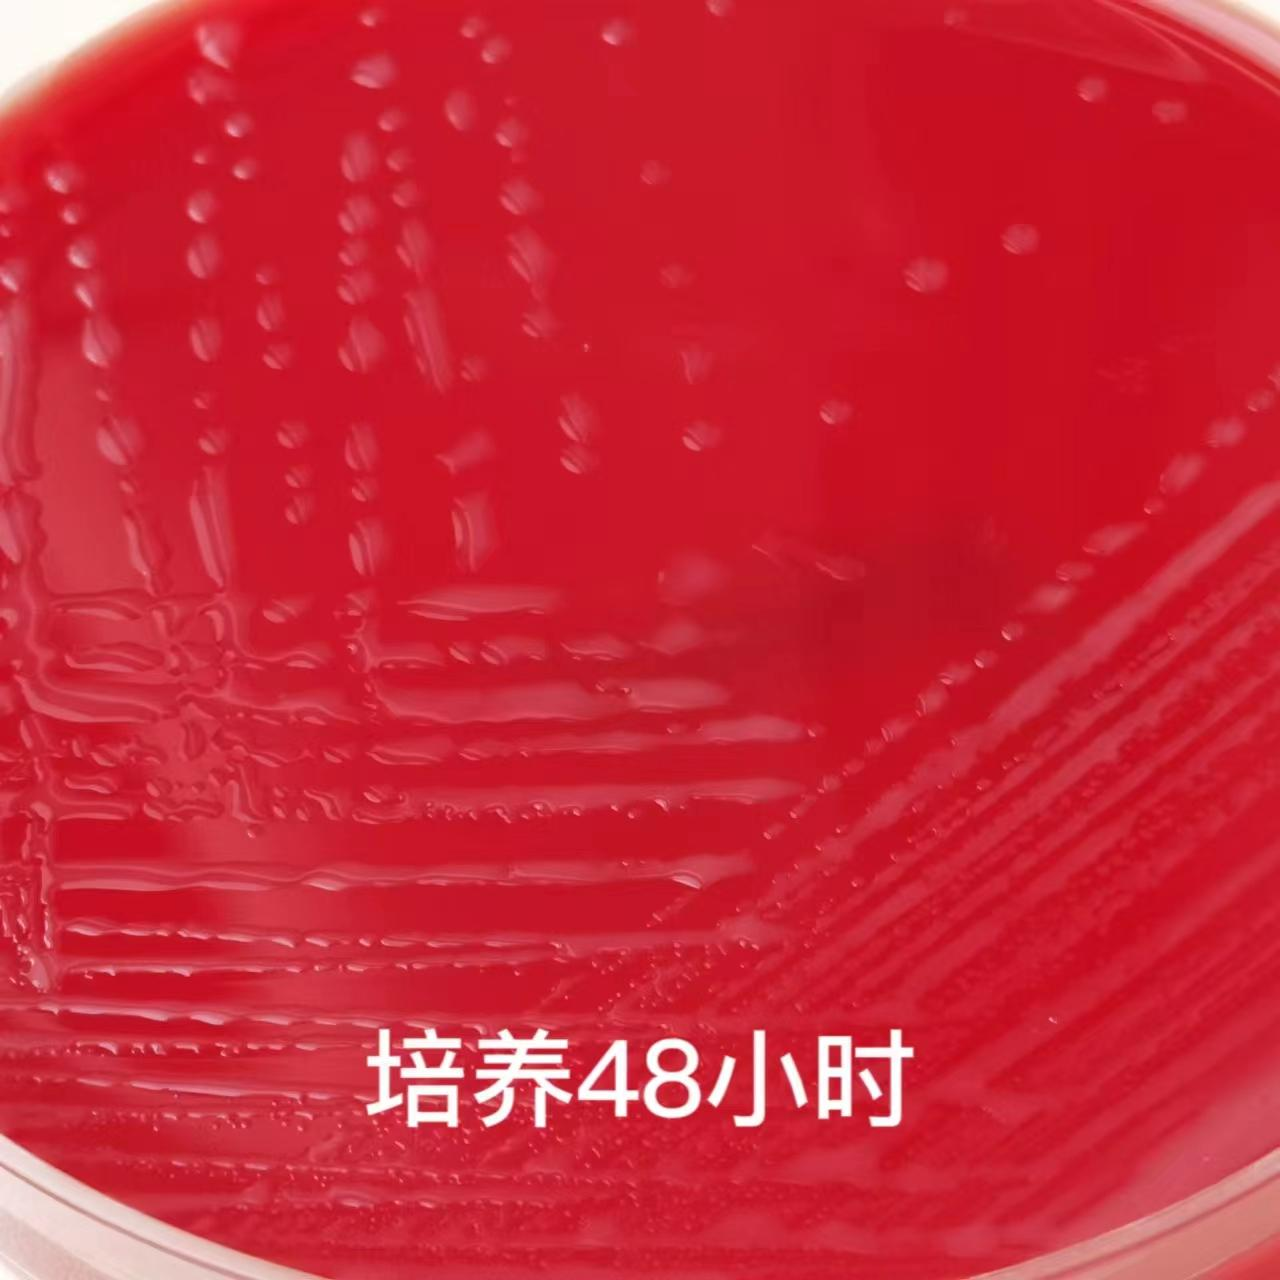

【第一百二十五期】基层检验网形态学培训
【第一百二十五期】基层检验网形态学培训
每周一次,每次几张,只要您坚持来,抽出几分钟的时间,相信您的识图能力会不知不觉的提升哦
1、陈某之女,1日,新生儿脑膜炎,血培养儿童瓶阳性,报阳时间12.36h,培养菌落形态、镜下形态及相关试验如下图,请结合图片资料判断最可能的细菌名称。



答案:无乳链球菌(B群链球菌)
解析:培养特性:在血琼脂平板上35℃培养18~24h,形成灰白色、表面光滑、有乳光、圆形、β溶血的菌落。部分菌株无β溶血环。
鉴别要点:革兰阳性球菌,菌落较小,有β溶血环,触酶试验阴性,CAMP试验阳性,箭头宽大。
临床意义:该菌是造成孕妇产褥期脓毒血症和新生儿脑膜炎的一个重要原因。它寄生在产妇生殖道,可致婴儿感染。也可引起产后感染、菌血症、心内膜炎、皮肤和软组织感染及骨髓炎。
2、余某之子,20日,早产儿,血培养儿童瓶阳性,报阳时间15.47h,培养菌落形态、镜下形态及相关试验如下图,请结合图片资料判断最可能的细菌名称。



答案:产单核细胞李斯特菌
解析:镜下形态:革兰阳性短杆菌,常呈V字型排列,偶有球状、双球状、无芽胞,无荚膜。
培养特性:在血琼脂平板上35℃培养18-24h,形成较小、圆形、光滑而狭窄β-溶血环的菌
落,在半固体培养基中均匀浑浊生长,呈倒伞状,能在4℃下缓慢生长。
鉴别要点:革兰阳性短杆菌,菌落较小,有狭窄β溶血环,CAMP试验阳性,呈长方形。
临床意义:该菌是一种人畜共患病的病原菌,感染后主要表现为败血症、脑膜炎等。它广泛
存在于自然界中,4℃的环境中仍可生长,是冷藏食品威胁人类健康的主要病原菌之一。该
菌进入人体后是否发病,与菌的毒力和宿主的年龄、免疫状态有关,因为该菌是一种细胞内
寄生菌,宿主对它的清除主要靠细胞免疫功能。因此,易感者多为新生儿、孕妇及老年人,免疫系统损伤或缺陷者、接受免疫抑制剂和皮质激素治疗的患者及器官移植者也易被该菌感染。
3、谭某,男,80岁,肺部肿瘤术后感染,痰样本涂片满视野白细胞,痰培养菌落形态、纯菌镜下形态及相关试验如下图,请结合图片资料判断最可能的临床致病菌名称。




答案:纹带棒杆菌
解析:镜下形态:革兰阳性棒杆菌,V形、栅栏状,单个或成双排列。
培养特性:在血琼脂平板上35℃培养18-24h,形成凸起、中等大小、奶油状、不溶血的圆
形菌落。
鉴别要点:革兰阳性棒杆菌,栅栏状排列,分解葡萄糖,触酶和马尿酸钠试验阳性,CAMP试验阳性,通常不如无乳链球菌、耳棒状杆菌的强烈。
临床意义:该菌一般是人或动物皮肤、鼻腔、咽喉部等处的正常菌群。近年来国外有学者报道,免疫抑制剂和现代化检查手段的广泛使用,导致纹带棒状杆菌所致的医院感染明显增多,可引起血流感染,应引起重视。
4、王某,男,56岁,养猪专业户,摔伤后脓性分泌物培养,菌落形态、纯菌镜下形态及相关试验如下图,请结合图片资料判断最可能的临床致病菌名称。

答案:马红球菌
解析:下形态:革兰阳性,卵圆形短杆菌,部分菌株弱抗酸染色阳性。
培养特性:在血琼脂平板上35℃培养18-24h,形成表面光滑、湿润、边缘整齐的橘黄至橙红色菌落,48h后色素更明显,菌落增大,随着时间的延长,可形成黏液型菌落。不溶血,不能发酵糖类、醇类,触酶阳性。
鉴别要点:镜下革兰阳性卵圆形短杆菌,部分菌株弱抗酸染色阳性,触酶阳性,CAMP试验阳性,阳性区域透亮,产橘黄或橙红色色素。
临床意义:该菌为马、猪、牛等动物的致病菌,可引起其肺部感染致化脓性肺炎而得名。在红球菌属中最常见,可引起人和动物感染,被认为是人类的条件致病菌,可引起人类呼吸感染、胸膜炎和菌血症等疾病。可经消化道和呼吸道感染,食用不熟的猪、牛、羊、马肉,特别是食用各种烤肉串使人致病,并可引起艾滋病、血液病和肾移植等免疫功能受损患者的肺部感染。
5、牟某,女,3岁,扁桃体化脓,吞咽困难,咽拭子培养菌落形态、纯菌镜下形态及相关试验如下图,请结合图片资料判断最可能的临床致病菌名称。




答案:溶血隐秘杆菌
解析:下形态:革兰阳性,不规则杆菌,细长,部分菌体有弯曲。
培养特性:在血琼脂平板上35℃培养48h后,形成直径0.5mm大小、凸起、半透明、β-溶血的菌落,可有粗糙和光滑两种菌落形态。
鉴别要点:革兰阳性不规则细长杆菌,部分菌体有弯曲,触酶试验阴性,反向CAMP试验
(CAMP抑制试验)阳性,指示菌区域表现为溶血抑制。
临床意义:该菌是人和家禽的专性寄生菌,能引起咽喉炎、扁桃体化脓或皮肤坏死,溶血隐秘杆菌可引起大龄儿童咽炎、伤口及软组织感染、骨髓炎、心内膜炎等。不同菌落特征与感染类型有关,呼吸道感染多为粗糙型菌落,深部组织感染往往是光滑型菌落。
感谢:重医大附一院检验科和重庆市垫江县人民医院提供的内容。


